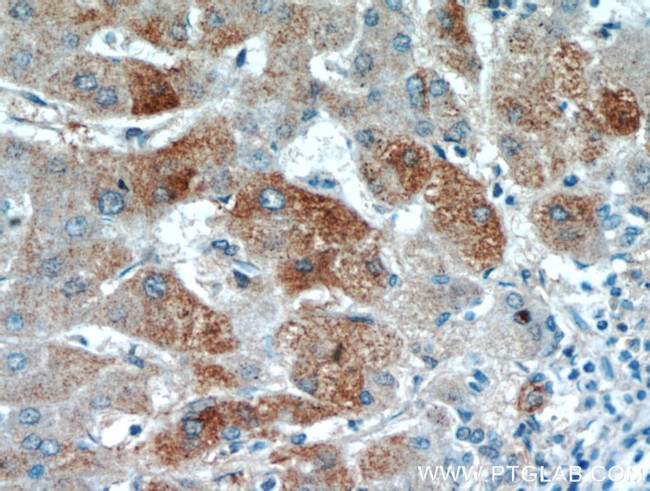
FAM101A Antibody in Immunohistochemistry (Paraffin) (IHC (P))

Search
Proteintech
FAM101A Polyclonal Antibody
{{$productOrderCtrl.translations['antibody.pdp.commerceCard.promotion.promotions']}}
{{$productOrderCtrl.translations['antibody.pdp.commerceCard.promotion.viewpromo']}}
{{$productOrderCtrl.translations['antibody.pdp.commerceCard.promotion.promocode']}}: {{promo.promoCode}} {{promo.promoTitle}} {{promo.promoDescription}}. {{$productOrderCtrl.translations['antibody.pdp.commerceCard.promotion.learnmore']}}
产品信息
21113-1-AP
种属反应
宿主/亚型
分类
类型
抗原
偶联物
形式
浓度
规格
纯化类型
保存液
内含物
保存条件
运输条件
产品详细信息
Immunogen sequence: MRPRMLPVF FGESIKVNPE PTHEIRCNSE VKYASEKHFQ DKVFYAPVPT VTAYSETIVA APNCTWRNYR SQLTLEPRPR ALRFRSTTII FPKHARSTFR TTLHCSLGRP SRWFTASVQL QLCQDPAPSL LGPATL (82-216 aa encoded by BC141805)
靶标信息
Involved in the regulation of the perinuclear actin network and nuclear shape through interaction with filamins. Plays an essential role in actin cytoskeleton formation in developing cartilaginous cells.
仅用于科研。不用于诊断过程。未经明确授权不得转售。
篇参考文献 (0)
生物信息学
蛋白别名: family with sequence similarity 101, member A; filamin-interacting protein FAM101A; protein FAM101A; Refilin-A; RefilinA; Regulator of filamin protein A; unnamed protein product
基因别名: 3110032G18Rik; cfm; CFM2; FAM101A; RFLNA
UniProt ID: (Mouse) Q7TS73, (Human) Q6ZTI6
Entrez Gene ID: (Mouse) 73121, (Rat) 689711, (Human) 144347